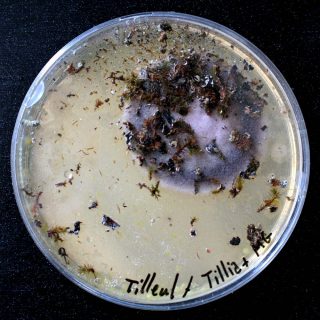
Community coalescence, installation, Karine Bonneval

L’exposition «Dialogue(s) avec un brin d’herbe » à la Maison des arts, centre d’art contemporain de Malakoff, convie dix-sept artistes contemporains à s’interroger sur les rapports qu’entretiennent l’art et le vivant.
«Dialogue(s) avec un brin d’herbe » : l’art incarne les nouveaux rapports entre l’homme et la nature
Alors que dans le cadre de son engagement pour favoriser le présence de la nature dans l’espace urbain, la ville de Malakoff a inauguré le 1er juin un verger dans le jardin du centre d’art, celui-ci engage un questionnement sur les nouvelles formes de dialogues qui se mettent en place entre les êtres humains et la nature. De nouvelles formes que l’art adopte également.
L’exposition explore le changement de paradigme du vingt-et-unième siècle qui voit la fin de l’opposition jusque là établie entre d’un côté l’étude de la nature et une pratique d’expérimentation réservées au corps scientifique et de l’autre, la pratique poétique, philosophique et politique. On assiste aujourd’hui à une hybridation des pratiques : le champ de la représentation scientifique et celui de la représentation politique ne sont plus indépendants mais génèrent au contraire une vision commune.
L’exposition rassemble des œuvres qui incarnent cette transversalité et l’ouverture de l’expérimentation à l’ensemble de la société, faisant de celle-ci un laboratoire à ciel ouvert. Les Beaucoup expérimentent, de plus en plus souvent d’ailleurs, avec des scientifiques. Les dix-sept artistes contemporains s’inscrivent dans une démarche mêlant art et sciences et génèrent de nouveaux paysages où humain et non-humain fusionnent, où l’homme n’est plus au cœur de tout et où ce qu’il crée réserve un espace au hasard et à l’inattendu.
Une démarche mêlant art et science
Les œuvres de Cécile Beau invitent à s’intéresser à l’invisible et à l’observer grâce à l’intensification de nos sens. L’installation Cladonia, qui place diverses variétés de mousses et de lichens sous une lampe de croissance et un brumisateur ultrason ou encore celle intitulée Still alive où une solution d’acide chlorhydrique, de vinaigre cristal et d’eau tombe par goutte-à-goutte sur des pierres calcaires, offre des expériences sensorielles où expérimentation scientifique et poésie se confondent. L’installation Pousse pousse ! de Martine Camillieri présente des boutures réalisées à partir de divers légumes et des boutures de plantes, formant un petit potager d’épluchures, propice à une réflexion sur les déchets que nous générons.
Les œuvres de Wilfrid Almendra explorent les relations entre le végétal et l’architecture par le biais d’installations qui incitent à porter un nouveau regard sur l’emprise de la végétation sur le bâti. Ainsi les sculptures de la série Concrete Gardens, des statues décoratives reproduisant des pièces classiques, récupérées par Wilfrid Almendra dans des zones pavillonnaires. Ayant subi les assauts du temps et de la nature, elles ont été délaissées par leurs propriétaires mais ont pourtant acquis une nouvelle beauté qui les éloigne de leur statut de simples copies.

parisART sur Instagram